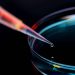
Die Welt heller und bunter machen Wir wollen Materiallösungen entwickeln, die die Grenzen des Möglichen überwinden.

Ein reproduzierbares Fluidmanagement, das an die vielfältigen Aufgaben in der Chromatographie angepasst ist, erfordert viel Erfahrung und ist praktisch ebenso aufwendig wie die Entwicklung der eigentlichen Chromatographie-Hardware. Bürkert bietet daher die Möglichkeit, das komplette Fluidmanagement auszulagern. Das breite Produktportfolio erlaubt dabei Lösungen aus einer Hand und reduziert so Reibungsverluste bei der Planung, Ersatzteilhaltung und Wartung.
Der Chromatographie-Gerätehersteller hat nun die Möglichkeit, das gesamte Fluidmanagement in die Hände der Bürkert-Experten zu geben, um sich auf seine eigentliche Kernkompetenz zu konzentrieren. Er erhält ein kompaktes, auf seine Anforderungen maßgeschneidertes Fluidmanagement, das ab Werk vollständig geprüft und sofort einsatzbereit ist. So ermöglicht beispielsweise eine kompakte Ventilplatte mit bis zu 240 Einzelventilen in Verbindung mit einer Schnellwechselvorrichtung den einfachen Austausch aller medienberührenden Teile und damit eine wirtschaftliche Stofftrennung bei höchster Reinheitsgarantie.
Ventilplatten als Disposables
Komplexe Fluidik-Systeme für die Chromatographie erfordern bei herkömmlichem Aufbau aufwendige Spül- und Reinigungsprozesse. Beim Konzept werden dagegen die Magnetventile als Vorsteuerventile auf eine Edelstahl-Grundplatte montiert, welche über eine vollflächige Membrane aus bspw. EPDM die einzelnen Kavitäten im mediumsführenden Manifoldblock aus PMMA schalten. Das ganze System ist in Layertechnologie aufgebaut und ermöglicht dadurch eine Medium-Führung ohne Totvolumina mit optimierter Kanalgestaltung. Ein weiterer großer Vorteil ist das einfache Wechseln der Kunststoffplatten als Disposables, das eine Kreuzkontamination beim Wirkstoffwechsel verhindert. Die gesamte Einheit wird als Einschub durch eine Hydraulikvorrichtung sicher und absolut dicht an die Vorsteuereinheit angepresst. Damit ist der gesamte medienführende Bereich bei Produktwechseln sehr schnell austauschbar.
Oberhalb der Pilotventile sind die modularen Elektronikplatinen zur Ventilsteuerung angebracht. Alle Komponenten werden über die hauseigene Geräteplattform EDIP (Efficient Device Integration Platform) miteinander verknüpft, der Anwender kann daher alle Parameter über die Software „Communicator“ oder übergeordnete Leitsysteme ansteuern. Das Unternehmen kümmert sich auch hier um die Schnittstellenkommunikation.